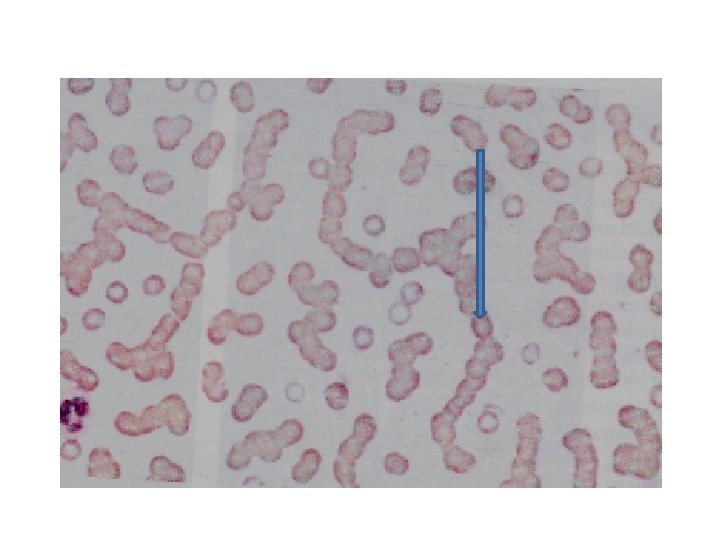

Multiple Myeloma DR zahida Qasim MBBS DCP MPhil


Multiple Myeloma DR. zahida Qasim MBBS, DCP, MPhil (Haematology)

ALL CLL Lymphomas MM naïv e B-lymphocytes Lymphoid progenitor AML Hematopoietic stem cell Myeloid progenitor Plasm a T-lymphocytes cells Myeloproliferative disorders Neutrophils Eosinophils Basophils Monocytes Platelets Red cells

B-cell development CLL stem cell lymphoid progenitor mature naive B-cell germinal center B-cell MM progenitor-B ALL memory B-cell pre-B immature B-cell DLBCL, FL, HL plasma cell

MULTIPLE MYELOMA Bone marrow……. Neoplastic proliferation of plasma cells Ch/by Bone Lytic lesions Serum and urine monoclonal protein BM

CLINICAL FEATURES OF MULTIPLE MYELOMA More than 90% of cases occur over the age of 40 with a peak incidence in the seventh decade. Bone pain (especially backache) and pathological fractures (fractures due to disease process and are usually not preceded by any trauma) Features of anemia: lethargy, weakness, dyspnoea, pallor, tachycardia, etc.

Recurrent infections, related to deficient antibody production Abnormal cell mediated immunity and Neutropenia. Features of renal failure and / or hypercalcemia (polydypsia, polyuria, anorexia, vomiting, constipation and mental disturbance) Abnormal bleeding tendency : Myeloma proteins may interfere with platelet function and coagulation proteins Thrombocytopenia occurs in advanced disease

LABORATORY FEATURES • Increased Plasma cells (Abnormal Plasma cells) in the bone marrow (more than 30%) • Anemia • Neutropenia • Thrombocytopenia • Rouleaux formation • Very high ESR • High calcium

Skull Xray in multiple myeloma showing ‘punched out lesions’

Serum protein electrophoresis in multiple myeloma showing an abnormal paraprotein in the Gamma globulin region

Raised urea & calcium Serum beta 2 Microglobulin is increased. Monoclonal Protein in serum and / or urine: The serum paraprotein is: Ig. G in two third Ig. M in one third Ig. A in one third Ig. M and Ig. D being rare Bence Jones Proteinuria Normal serum immunoglobulins are reduced (immunoparesis)

• Urine contains Bence Jones Protein (Free light chains) • Bone lesions • Skeletal surveys show Osteo lytic lesion • osteoporosis , pathological fractures and vertebral collapse are common.

TREATMENT I. SPECIFIC TREATMENT: 1. Chemotherapy: (i) Alkalyting Agents- Melphalan: Given orally (ii)Steroids: Are usually given along with alkalyting agents (iii) Cyclophosphamide: Can be used as a single agent with monthly administration. (iv) Vincristine + Adrimycin+ Dexamethasone (VAD): .

2. Thalidomide: In relapsed cases. 3. Alpha – Inteferon 4. Radiotherapy: Used for areas of bone pain or spinal cord compression. 5. Stem Cell Transplantation

II. SUPPORTIVE TREATMENT: 1. Treatment of renal failure 2. Bisphonates (Antiosteoclastic) 3. To treat dehydration produced by hyperclacemia. 4. Antibiotics to treat infections 5. Red cells concentrates for anaemia. 6. Platelet concentrates in cases with bleeding due to thrombocytopenia.

- Slides: 19